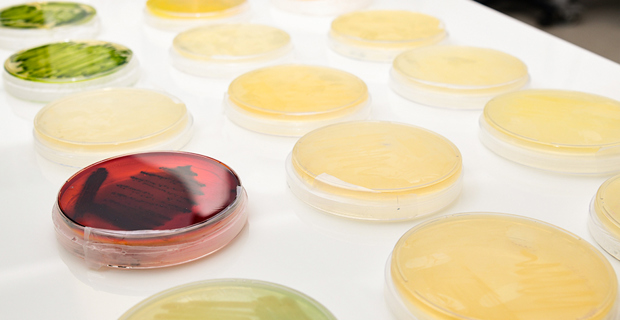
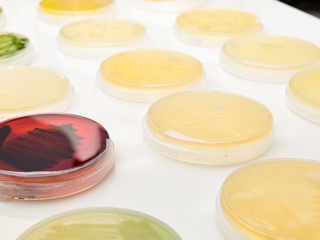

Erzurum Teknik Üniversitesi (ETÜ) laboratuvarlarında hazırlanan proje TÜBİTAK 1001 Bilimsel ve Teknolojik Araştırma Projeleri Destekleme Programı kapsamında destek almaya hak kazandı
ETÜ Fen Fakültesi öğretim üyelerinden Dr. Öğretim Üyesi Ayşenur Yazıcı tarafından hazırlanan “Küçük, Katyonik Özellikli Antibiyofilm Peptitlerin Dizaynı, Karakterizasyonu ve Biyolojik Fonksiyonlarının in vitro ve in vivo Şartlarda İncelenmesi” başlıklı proje ile biyoinformatik olarak özelikleri belirlenen peptitlerin in vitro ve in vivo çalışmalarla doğrulanması ve antibiyotik direncine karşı kullanılabilecek yeni antibiyofilm peptitlerin ortaya çıkarılması hedefleniyor. Doç. Dr. Serkan Örtücü ve Dr. Öğr. Üyesi Mehmet Enes Arslan’ın da araştırmacı olarak yer aldığı projede aynı zamanda 3 lisansüstü öğrencisi de bursiyer olarak görev alacak.
Antibiyotik dirençliliğin günümüzde küresel bir sağlık problemi haline geldiğini ifade eden proje yürütücüsü Dr. Öğretim Üyesi Yazıcı, “Antibiyotiklerin yanlış, fazla ve gereksiz kullanımı antibiyotik direncinin gelişmesinde önemli bir etkendir. Bununla birlikte, bakteriler arasında meydana gelen yatay gen transferleri, mutasyonlar, ilaç hedeflerinin modifikasyonu ve biyofilm oluşumu direnç mekanizmalarının gelişmesinde önemli etkenler arasında gösterilmektedir. Özellikle biyofilm kaynaklı enfeksiyonlarda, antibiyotiklerin yetersiz kalması, bu problemin ciddi olarak ele alınması gerekliliğini göstermektedir. Özellikle biyofilm kaynaklı enfeksiyonlarda, antibiyotiklerin yetersiz kalması, bu problemin ciddi olarak ele alınması gerekliliğini göstermektedir. Günümüzde enfeksiyonların %80’den fazlasının biyofilm kaynaklı olduğu bildirilmektedir. Bu problemi çözmeye yönelik geliştirilen antimikrobiyal peptitler (AMP’ler), antibiyotik direnci için kullanılması muhtemel yeni nesil ilaç adaylarıdır” şeklinde konuştu.
Kurumsal İletişim ve Tanıtım Direktörlüğü 7.09.2022